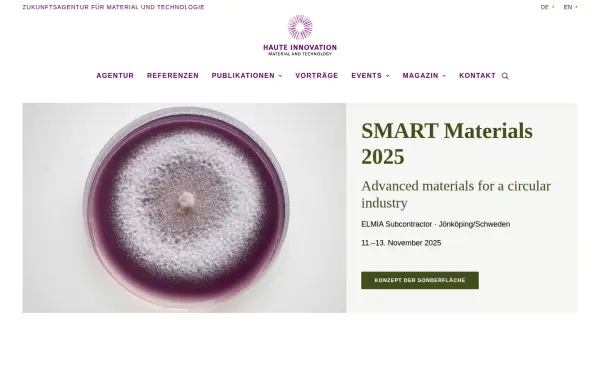
www.haute-innovation.com

www.haute-innovation.com
Haute Innovation – Zukunftsagentur für Material und Technologie - Haute Innovation
Sprache: Deutsch
Description: Die Zukunftsagentur Haute Innovation ist spezialisiert auf nachhaltige Materialien, additive Produktion, smarte Werkstoffe und Materialinnovationen.
Generator: WP Rocket 3.19.1.2
Robots-Anweisung: follow, index, max-snippet:-1, max-video-preview:-1, max-image-preview:large
Viewport: width=device-width, initial-scale=1
Sicherheit und Einstufung
Die Website enthält laut CLOUDFLARE keine bedenklichen Inhalte und kann sowohl von Minderjährigen als auch in der Arbeit genutzt werden.
Rechtliches / Kontakt
Impressum:
https://www.haute-innovation.com/impressum/
Kontakt:
https://www.haute-innovation.com/kontakt/
Der Betreiber dieser Domain befindet sich in 10961 Berlin
Sämtliche Sub-Domains der Haupt-Domain
haute-innovation.com
haute-innovation.com
,
www.haute-innovation.com
Verwendete Technologien
-
Apache HTTP Server
Apache ist eine freie und quelloffene, plattformübergreifende Webserver-Software.
-
jQuery
jQuery ist eine JavaScript-Bibliothek, eine kostenlose Open-Source-Software, die das Traversieren und Manipulieren des HTML-DOM-Baums sowie die Ereignisbehandlung, CSS-Animation und Ajax vereinfacht.
-
MySQL
MySQL ist ein quelloffenes relationales Datenbankmanagementsystem.
-
Open Graph
Open Graph ist ein Protokoll, das dazu dient, jede beliebige Webseite in den Social Graph zu integrieren.
-
PHP
PHP ist eine universelle Skriptsprache für die Webentwicklung.
-
Priority Hints
Priority Hints bietet Entwicklern einen Mechanismus, um Browsern eine relative Priorität zu signalisieren, die sie beim Abrufen von Ressourcen berücksichtigen können.
-
PWA
Progressive Web-Apps (PWAs) sind Web-Apps, die mit modernen APIs erstellt und erweitert werden, um verbesserte Funktionen, Zuverlässigkeit und Installationsmöglichkeiten zu bieten und gleichzeitig jeden, überall und auf jedem Gerät zu erreichen - und das alles mit einer einzigen Codebasis.
-
RankMath SEO
RankMath SEO ist ein Plugin zur Suchmaschinenoptimierung für WordPress.
-
Typekit
Typekit ist ein Online-Dienst, der eine abonnierte Bibliothek von Schriftarten anbietet.
-
WordPress
WordPress ist ein kostenloses und quelloffenes Content-Management-System, das in PHP geschrieben und mit einer MySQL- oder MariaDB-Datenbank gekoppelt ist. Zu den Funktionen gehören eine Plugin-Architektur und ein Vorlagensystem.
-
WPML
Das WPML-Plugin ermöglicht den Aufbau und Betrieb vollständig mehrsprachiger WordPress-Websites.
-
WP Rocket
WP Rocket ist ein Caching- und Performance-Optimierungs-Plugin zur Verbesserung der Ladegeschwindigkeit von WordPress-Websites.
-
Adobe Fonts
Adobe Fonts ist ein webbasierter Dienst, der Zugang zu einer umfangreichen Bibliothek mit hochwertigen Schriften für Web- und Printdesign bietet.